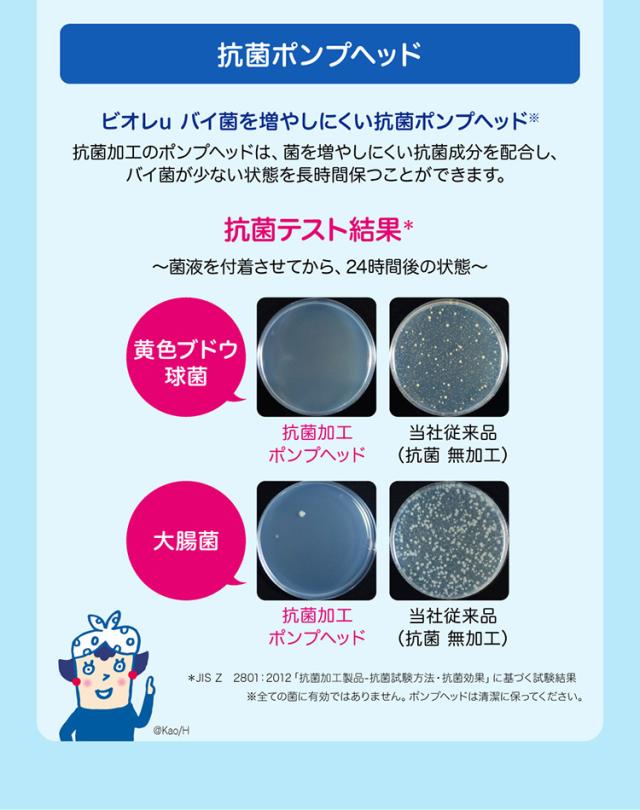

ビオレu 泡ハンドソープ つめかえ用(770ml*3本セット)[泡ハンドソープ]
Pontaパス特典
サンキュー配送
1,980円(税込)
0ポイント(1%)
商品説明

※説明文は単品の内容です。
商品に関するお問合せ
受付時間 9:00〜17:00(土曜・日曜・祝日を除く)
*製品の誤飲・誤食など緊急の場合は、受付時間外でもお電話ください
ヘアケア・スキンケア用品:0120-165-692
男性化粧品(サクセス):0120-165-694
ニベア・8*4:0120-165-699
ソフィーナ・エスト:0120-165-691
キュレル:0120-165-698
洗たく用洗剤・仕上げ剤・そうじ用品・食器用洗剤:0120-165-693
ハミガキ・洗口液・入浴剤・温熱シート:0120-165-696
紙おむつ・生理用品・サニーナ:0120-165-695
飲料(ヘルシア):0120-165-697
Sonae(そなえ):0120-824-450
ペットケア:0120-165-696
リニューアルに伴い、パッケージ・内容等予告なく変更する場合がございます。予めご了承ください。
商品区分:医薬部外品
【ブランド】
ビオレU(ビオレユー)
【発売元、製造元、輸入元又は販売元】
花王
【ビオレu 泡ハンドソープ つめかえ用の商品詳細】
●1プッシュですみずみまで洗いやすいながもっち泡!「ビオレu 泡ハンドソープ」のつめかえ用です。
●殺菌成分配合。汚れ、ウイルス・細菌を除去。※すべての菌に効果があるわけではありません。
●素肌とおなじ弱酸性。
●SPT(肌清浄化技術)採用。
●カサつきがちな手肌も、うるおいを守って洗えます。
●手に香りが残りにくく、すっきりとしたマイルドシトラスの香り。
【販売名】ビオレu Hg
・単品JAN:4901301416001
品番:561722
【成分】
| イソプロピルメチルフェノール*、水、ポリオキシエチレンラウリルエーテル硫酸アンモニウム(1E.O.)液、PG、エタノール、PEG6000、POEラウリルエーテル酢酸、グリセリルエチルヘキシルエーテル、アクリルアミド・アクリル酸・塩化ジメチルジアリルアンモニウム共重合体液、塩化トリメチルアンモニオヒドロキシプロピルヒドロキシエチルセルロース、エデト酸塩、乳酸、水酸化ナトリウム液、安息香酸塩、香料 *は「有効成分」無表示は「その他の成分」 |
【注意事項】
・湿疹、皮フ炎(かぶれ、ただれ)等の皮フ障害のある時は使わない。
・かぶれ、刺激等の異常が出たら使用を中止し、皮フ科医へ相談する。使い続けると症状が悪化することがある。
・目に入った時は、すぐに充分洗い流す。
ビオレu 泡ハンドソープ つめかえ用に関する詳細なお問合せは下記までお願いします
花王
103-8210 東京都中央区日本橋茅場町1-14-10 ※お問合せ番号は商品詳細参照
ショップ名 爽快ドラッグ
1プッシュですみずみまで洗いやすい「ながもっち泡」
レビュー
商品の評価:



 -点(0件)
-点(0件)









